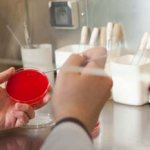
image

Бактериологический посев (бакпосев) – это микробиологическое лабораторное исследование биологического материала человека путем его посева на определенные питательные среды при определенном температурном режиме с целью выявления наличия в нем любого количества патогенных и условно-патогенных микроорганизмов и дальнейшего решения задач специфического лечения.
Бакпосев
При выделении определенных микроорганизмов проводится второй немаловажный анализ – антибиотикограмма – определение чувствительности обнаруженных патогенов к антибактериальным препаратам и бактериофагам.
Показания
Обычно доктора назначают анализ на посев в гинекологии в следующих случаях:
- На фоне жалоб на боль внизу живота в сочетании с неприятными ощущениями в районе половых органов, зудом, необычными выделениями из влагалища и так далее.
- В рамках профилактического обследования у гинеколога раз в шесть месяцев.
- Планирование женщиной рождения ребенка и беременность.
- Длительная терапия антибиотиками, различными гормонами или цитостатиками.
- Фактор смены полового партнера.
К исследованию необходимо тщательно готовиться.
Особенности проведения бактериального посева из влагалища
Дополнением баканализа считается копрологический анализ кала. Данное исследование позволяет оценить наличие специфического запаха фекалий, его консистенцию и плотность, общий вид, присутствие либо отсутствие микроорганизмов.
У детей грудничкового и младшего возрастов нормы содержания бактерий в кале отличаются от взрослых норм. Кишечник маленьких детей не содержит того количества микроорганизмов, которое содержится во взрослом кишечнике. У 75% детей при переходе на искусственное кормление наблюдается дисбактериоз и расстройства кишечника.
Для уменьшения дискомфорта женщине рекомендуют расслабиться. Напряженность при использовании зеркала часто вызывает неприятные ощущения.
Если же никаких колоний бактерий не выделено, то и антибиотикограмма не проводится (но стоимость одинаковая).
Подготовка к анализу на посев в гинекологии
Непосредственно перед визитом к гинекологу для сдачи данного анализа следует соблюсти следующие требования:
- Нужно на два дня воздержаться от половых контактов.
- Нельзя применять вагинальные средства (крем, свечи) и осуществлять спринцевания в течение двух суток.
- Перед анализом на посев рекомендуется в течение двух часов не мочиться.
Желательно сдавать мазок женщинам сразу после месячных, на четвертый или пятый день цикла.
Расшифровка мазка на флору у женщин
В норме во взятом биоматериале определяют палочковую флору с единичными лейкоцитами. Кокковое преобладание, а также большой объем лейкоцитов (воспалительные клетки) и эритроцитов присутствуют при воспалительных процессах. Обнаружение в биоматериале трихомонад говорит о трихомониазе, гонококков — о гонорее. Нередко обнаруживают нити мицелия, то есть кандидоз, который еще называют молочницей.
Расшифровка мазка на флору у женщин дает возможность определять видовую принадлежность и число бактерий. Благодаря этому также удается установить чувствительность к антибактериальным средствам.
Каким образом проводится процедура
Анатомические особенности женской уретры довольно специфичны. Все это говорит о том, что процедуру соскоба обязан проводить опытный специалист. Принято различать два вида мазка у женщин: инструментальный метод и ручной.
Если говорить о первом способе, то он заключается в введении в уретральный канал специального аппликатора с намотанным на него стерильным тампоном. Доктор прижимает этот инструмент к стенке канала, а после вращает и извлекает.
Ручной способ менее неприятный, потому что специалист вводит палец во влагалище, надавливая тем на переднюю стенку уретры. В результате выделяется секрет, который осторожно собирают.
Нужно отметить, что расшифровкой мазка из уретры у женщин занимается опытный доктор, который в случае каких-то отклонений всё разъяснит и назначит лечение, если в этом будет необходимость.
Плоский эпителий
Если при рассмотрении биологического материала в поле зрения находится не больше 10 клеток, тогда все нормально. Этот показатель всегда присутствует в мазке, так как данные клетки регулярно обновляются.
Если он присутствует в большом количестве, больше десяти в поле зрения, тогда такое увеличение числа эпителиальных клеток служит признаком наличия воспалительных процессов во влагалище.
Если плоский эпителий не обнаружен вовсе, можно предположить сбой гормонального фона у женщины наряду с недостаточным количеством эстрогенов. Это считается косвенным симптомом атрофии влагалищной слизистой.
Зачем нужен бакпосев
Данный метод исследования производится путем посева биологического материала человека на определенные питательные среды, которые создают в лаборатории. Через определенное количество времени биоматериал «обрастает» микроорганизмами, в последствии их тестируют на чувствительность к противомикробным средствам и антибиотикам. По результатам анализа составляется антибиотикограмма, которая показывает, от какого препарата быстрее всего погибает возбудитель. Эта информация используется для назначения лечения. Бак посев на микрофлору широко применяется для выявления причины различных инфекций и воспалений. Он помогает идентифицировать возбудителя и подобрать наиболее эффективное лекарство.
Концентрация микроорганизмов в биоматериале измеряется в КОЕ/мл (колониеобразующих единицах).
Этот метод исследования имеет несколько недостатков: — длительность выполнения, — необходимость стерильности при заборе биоматериала, — из-за недостаточной квалификации лаборанта или длительной транспортировки материала результаты бактериального посева могут быть неточными.
Золотистый стафилококк
В норме полное отсутствие посторонней флоры считается признаком высокой степени чистоты женских органов. Если обнаружено меньше десяти условно-патогенных посторонних микроорганизмов, тогда подобное вполне допустимо, но только при условии нулевых признаков воспаления.
Когда показатель золотистого стафилококка и лейкоцитов составляет больше пятнадцати, подобное говорит о наличии большого числа кокков, лейкоцитов и воспалительных клеток. Причем речь в данном случае идет о гнойных процессах во влагалище, равно как и в цервикальном канале.
Выделение штаммов и изучение чистых культур
Выделение штаммов не всегда одинаково, поскольку некоторые биологические среды, находящиеся в человеческом организме требуют индивидуального подхода, например, гемокультуру (кровь) сначала в жидкой среде (соотношение 1 : 10) немного «подращивают», поскольку кровь (неразведенная) может убить микроорганизмы, а затем, через сутки или больше, пересевают на чашки Петри.
Посев мочи, промывных желудочных вод и других жидких материалов тоже имеет свои особенности, где для получения чистой культуры, жидкость сначала следует центрифугировать (условия – асептические!), а уж затем сеять, причем не саму жидкость, а ее осадок.
Культивирование и выращивание колоний осуществляют на чашках Петри или помещают сначала в жидкую среду, разлитую в стерильные флакончики, а затем изолированные колонии еще раз высевают, но уже на скошенный агар и помещают материал на сутки в термостат. Убедившись в чистоте полученной культуры, штаммы переносят на предметное стекло, делают мазок и окрашивают по Граму (чаще всего), Цилю-Нильсену и др. и для дифференцировки изучают морфологию микроба под микроскопом:
- Размер и форму бактериальной клетки;
- Наличие капсул, жгутиков, спор;
- Тинкториальные свойства (отношение микроорганизма к окрашиванию)*.
Мазок при беременности
В период вынашивания плода у женщин неоднократно осуществляется взятие мазка на микрофлору из урогенитального тракта, потому так как любые воспалительные процессы могут сказываться на здоровье ребенка. Исследование флоры проводят посредством изучения биоматериала, который берут из трех мест: слизистая влагалища, цервикальный канал и уретра.
Половые наружные органы, шейка матки и влагалище женщины служат родовыми путями, по которым плод проходит. В случае установления в мазке воспалительного процесса появляется риск инфицирования малыша во время родов наряду с заселением кишечника и кожи патологической микрофлорой и возникновением всевозможных заболеваний.
При наличии неблагоприятного результата анализа на посев при беременности (в гинекологии он является распространенным видом исследования) в первых двух триместрах высока вероятность развития инфицирования плодной оболочки и вод (дело в том, что патогенная флора легко проникает через цервикальный канал в полость матки). Не исключается поражение плаценты и появление внутриутробных инфекций плода. Вследствие всего этого беременность может заканчиваться спонтанным выкидышем, наступлением преждевременных родов. Помимо всего прочего, может нарушиться механизм формирования вод (маловодие). Существует также риск фетоплацентарой недостаточности и внутриутробной задержки развития.
Кроме этого патологическая микрофлора половых протоков у женщин оказывает влияние и на общий характер послеродового периода. Возрастают риски развития гнойных и септических осложнений (возможно нагноение швов промежности и появление эндометрита и сепсиса). Взятие контрольного анализа позволяет оценивать эффективность проводимой терапии.
Плохой мазок в последнем триместре крайне опасен инфицированием плодной оболочки и ее ранним разрывом, что приводит к преждевременным родам, а кроме того, к инфицированию плода. Кроме этого кольпитом в последнем периоде беременности разрыхляются родовые пути, они могут отекать и легко травмируются, что ведет к многочисленным травмам промежности, шейки и влагалища.
Занятие 6 Тема: Инъекции Набор лекарственных средств из ампул и флаконов
Цель:
введение пациенту лекарственного раствора.
Оснащение:
на лотке: шприц с иглой, игла для инъекции, ватные шарики, пинцет в крафт-пакете; лекарственный раствор в ампулах и флаконах, стеклорез, нестерильный пинцет или ножницы, раствор 70%-ного этилового спирта, лоток для отработанного материала.
Последовательность действий
После сборки шприца медицинская сестра остается в перчатках и маске.
/. Набор лекарственного раствора из ампулы.
- Уточнить название, концентрацию, срок годности приготовленного лекарственного средства, сравнить с назначением врача.
- Встряхнуть ампулу, чтобы раствор оказался в широкой ее части.
- Стерильным пинцетом взять ватный шарик, пинцет вернуть в крафт-пакет, шарик смочить спиртом.
- Надпилить узкую часть ампулы стеклорезом и протереть шариком со спиртом.
- Вскрыть ампулу, отломив надпиленную часть шариком, смоченным спиртом.
- Вскрытую ампулу поставить на стол, шарик сбросить в лоток для отработанного материала.
- Открыть стерильный лоток, взять шприц в правую руку.
- Взять ампулу в левую руку между вторым и третьим пальцами.
- Ввести иглу в просвет ампулы, не касаясь ее краев снаружи.
- Оттянуть поршень на себя и набрать необходимое количество раствора.
- Положить пустую ампулу в лоток для отработанного материала.
- Снять свободной рукой иглу, через которую набирали раствор, и положить ее в лоток для отработанного материала.
- Пинцетом взять иглу для инъекции, надеть ее на подыгольный конус шприца и закрепить ее (притереть).
- Положить пинцет в крафт-пакет.
- Проверить проходимость иглы, пропустив через нее 1-2 капли лекарственного раствора (шприц находится в вертикальном положении).
- Положить шприц на лоток, накрыть салфеткой.
//. Набор лекарственного раствора из флакона.
- Уточнить название, концентрацию, срок годности приготовленного лекарственного раствора, сверить с назначением врача.
- Отметить на этикетке дату, время вскрытия флакона, поставить свою подпись.
- Вскрыть (нестерильным пинцетом, ножницами) центральную часть алюминиевой крышки флакона.
- Взять стерильным пинцетом стерильный ватный шарик.
- Пинцет положить в крафт-пакет, шарик смочить спиртом.
- Обработать шариком, смоченным спиртом, резиновую пробку флакона, шарик сбросить в лоток для отработанного материала.
- Открыть стерильный лоток, взять шприц с иглой в правую руку.
- Проколоть резиновую пробку флакона иглой.
- Перевернуть флакон вверх дном, слегка приподняв и придерживая его пальцами левой руки.
10.Набрать необходимое количество лекарственного раствора, оттягивая поршень.
11.Снять флакон вместе с иглой с подыгольного конуса шприца, придерживая поршень, флакон поставить на стол.
12.Взять стерильным пинцетом иглу для инъекции, надеть ее подыгольный конус, закрепить ее, пинцет положить в крафт-пакет.
- Проверить проходимость иглы, пропустив через нее 1-2 капли раствора.
- Положить шприц на лоток, накрыть салфеткой.
Лечение беременных при наличии плохого мазка
При патологическом результате анализа на посев в гинекологии назначается лечение. Во время вынашивания предпочтение отдают местной терапии, что понижает вероятность негативного эффекта медикаментозных средств на плод. Лечение напрямую зависит от установленного возбудителя и протекает, как правило, в два этапа. Первый предполагает назначение этиотропной терапии, которая направлена на устранение причин патогенного мазка, а второй преследует цели восстановления нормальной влагалищной микрофлоры.
В случае выявления в мазке трихомонад в начальном триместре женщинам назначают спринцевания с помощью таких растворов, как «Фурациллин», перманганат калия. Также подходят отвары лекарственных трав. Со второго триместра требуется интравагинальный ввод свечей, содержащих метронидазол (это препараты «Тержинан», «Клион-Д»). Пероральное использование препаратов, включающих этот лечебный компонент, разрешается в последнем периоде вынашивания (например, «Трихопол» или «Орнидазол»).
Бактериальный вагиноз при наличии беременности на раннем сроке лечится тампонами, содержащими клиндамицин, во втором триместре беременности женщинам назначают свечи «Тинидазол». В случае выявления гонореи показана терапия антибиотиками, принадлежащими к цефалоспориновому ряду («Цефиксим» или «Цефтриаксон»).
Лечение молочницы в себя включает ввод свечей, обладающих противогрибковой активностью (речь идет о «Гино-Певариле», «Клотримазоле», «Пимафуцине»). На позднем сроке пьют таблетки «Флуконазол». Второй этап терапии включает в себя назначение пробиотиков интравагинальным методом (свечи, а также тампоны, к примеру «Бифидумбактерин», «Лактобактерин», «Апилак» или «Бифидин»). Продолжительность терапии составляет от десяти до четырнадцати дней.
Таким образом, мы разобрались, что такое посев в гинекологии. Мазок на заболевания урогенитальной сферы выступает одним из наиболее распространенных, а вместе с тем и информативных методов исследования в современной медицине. Благодаря ему можно не только выявлять банальное воспаление, но дополнительно предупреждать развитие всевозможных онкологических заболеваний. Несмотря на надежность, а кроме того, доступность методики, далеко не все женщины осознают потребность в регулярном посещении гинеколога и сдаче соответствующих анализов и, к сожалению, обращаются к доктору только в крайне запущенных случаях.
Что представляет собой бактериологический посев?
Материал для исследования в бактериологической лаборатории помещают (делают посев) на специальные питательные среды. В зависимости от желаемого поиска того или иного возбудителя или группы возбудителей посев производится на разные среды. Например, это может быть избирательная или элективная питательная среда (для роста какого-то одного возбудителя, рост других микробов при этом угнетается), примером которых может быть свернутая лошадиная сыворотка для выявления возбудителей дифтерии или среда с селенитом или с солями желчных кислот для обнаружения кишечных возбудителей.
Другим примером могут быть дифференциально-диагностические среды (среда Гисса), которые используются для расшифровки бактериальных культур. При необходимости с жидких питательных сред делают пересев на твердые среды с целью большей идентификации колоний.
Бакпосев. Колонии на твердой среде
Затем питательные среды помещают в термостат (специальный прибор), в котором создаются благоприятные условия (температура, влажность и др.) для роста и размножения возбудителей, в термостате среды находятся определенное время.
Далее проводят контрольный осмотр выросших колоний микроорганизмов, которые называют «культурой микроорганизмов». При необходимости проводят микроскопию материала колоний с предварительной окраской специальными красителями.
Что оценивается при контрольном осмотре? Это форма, цвет, плотность колоний, после дополнительного исследования – способность разлагать некоторые неорганические и органические соединения.
Далее проводят подсчет возбудителей. При микробиологической исследовании учитывается такое понятие, как колониеобразующая единица (КОЕ) — одна микробная клетка, способная образовать колонию, или видимая колония микробов. По КОЕ возможно определить концентрацию или количество микроорганизмов в исследуемом образце. Подсчет КОЕ проводится разными методами: подсчетом колоний под микроскопом, методом серийных разведений, секторным методом.